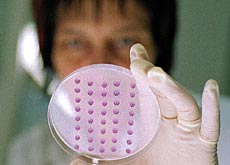

Una dimostrazione di maturità politica
Con il sì alla legge sulle cellule staminali, i cittadini lasciano aperta la porta alla ricerca fondamentale. Evitato l’amalgama con la clonazione.
Anche per la nuova perequazione finanziaria gli elettori hanno seguito le indicazioni di governo e parlamento.
La legge sulle cellule staminali ce l’ha fatta. Nelle settimane che hanno preceduto il voto i fautori del no sembravano aver guadagnato terreno, ma alla fine il popolo ha dato ragione al governo: la ricerca fondamentale s’ha da fare ed è meglio farla in un quadro regolato in modo chiaro e restrittivo da una legge che senza nessun tipo di controllo statale.
È difficile dire quanto abbiano pesato sul piatto della bilancia le promesse di nuove cure per le malattie degenerative. In definitiva, gli stessi ambienti scientifici hanno riconosciuto a più riprese che non ci sono ancora applicazioni pratiche all’orizzonte per le cellule “onnipotenti” (così potrebbero essere definite le staminali embrionali, che racchiudono in loro la possibilità di svilupparsi in qualsiasi altra cellula del corpo).
La volontà di non porre ostacoli al progresso della medicina è stata tuttavia una delle ragioni per le quali, soprattutto nella Svizzera francese, molti cittadini hanno deposto un sì nelle urne.
Non bloccare la ricerca
Più incisive sembrano essere state le riflessioni sull’atteggiamento della Svizzera nei confronti della ricerca scientifica. Vogliamo sapere come funzioniamo? Allora dobbiamo concedere agli scienziati di studiare anche le cellule staminali. Ciò che faremo in seguito con le conoscenze acquisite è un altro paio di maniche.
Le riserve sollevate dai verdi e da parte della sinistra – con questo tipo di ricerca si aprirebbe la porta a nuove forme di eugenismo e alla clonazione – non hanno fatto breccia. L’elettore svizzero sa che se si dovesse arrivare a questo punto sarebbe di nuovo chiamato alle urne e che un domani, almeno teoricamente, potrà sempre dire no alla clonazione.
Al momento sembra più importante non perdere il contatto con la comunità scientifica internazionale – che lavora in base a leggi meno severe di quella approvata in Svizzera – e arginare la fuga di cervelli. Se questo andrà anche a vantaggio dell’industria farmaceutica elvetica è ancora da stabilire.
Un voto poco emotivo
Non sono stati accolti nemmeno gli argomenti degli ambienti conservatori che, così come avevano combattuto la legge sull’interruzione di gravidanza, si sono schierati contro la strumentalizzazione degli embrioni a scopo di ricerca, ritenendo che ogni forma di vita umana vada difesa.
Ma questa volta, l’emotività che aveva caratterizzato il voto sull’aborto non si è ripresentata. Anche nei cantoni a maggioranza cattolica – quelli che avevano avuto più difficoltà ad accettare la soluzione dei termini – sembrano aver prevalso le considerazioni pratiche.
Se le leggi del paese autorizzano la fecondazione in vitro, se questa tecnica è imperfetta e dà origine a degli embrioni soprannumerari, se questi embrioni soprannumerari devono essere lasciati morire, allora tanto vale che vengano “distrutti” per la ricerca sulle cellule staminali, ricerca dalla quale ci si aspettano dei benefici.
Federalismo, autonomia e solidarietà
La nuova perequazione finanziaria aveva necessitato 10 anni di lavori ed era riuscita a mettere d’accordo governo, parlamento e cantoni. Un consenso su un tema molto complesso, che ha finito per convincere anche il popolo – almeno la parte che si è recata alle urne.
A guadagnarci dovrebbe così essere il federalismo, con una bella spolverata dell’attuale sistema di suddivisione delle competenze, che risale a quasi 50 anni fa. Un sistema che con il tempo ha dimostrato i suoi limiti, dato che il divario fra cantoni ricchi e poveri è andato crescendo. Questo risultato rinsalda anche la solidarietà fra le regioni del paese.
Tutti i governi cantonali, con l’unica eccezione del ricco Zugo, hanno riconosciuto nel nuovo impianto di perequazione finanziaria novità interessanti. Il nuovo modello, infatti, non tiene conto soltanto delle spese che gravano sui cantoni di montagna, ma anche dei carichi sociali che i centri urbani devono accollarsi. Ma la nuova perequazione inietta anche nuova autonomia nei cantoni, che negli ultimi anni si erano visti ritirare dallo stato centrale parecchie competenze. Inoltre, in caso di insuccesso, la Confederazione minacciava di intervenire con mano pesante, provocando più costi di quanto provocherà in definitiva la nuova perequazione.
Opposizione divisa
La sinistra, che temeva un ulteriore smantellamento sociale, era partita in battaglia tutt’altro che compatta: numerose sezioni cantonali del Partito socialista, in contrasto con la direzione nazionale, avevano approvato la proposta.
Anche le associazioni di disabili non hanno trovato un piano comune. Si sono divise tra chi ha visto il pericolo di tagli al finanziamento delle istituzioni e chi ritiene invece che gli handicappati saranno stimolati per agire in modo più autonomo e responsabile.
Il parlamento dovrà ora discutere le leggi necessarie alla realizzazione della nuova perequazione, che dovrebbe entrare in vigore il 1° gennaio 2008
Swissinfo, Doris Lucini e Mariano Masserini
La legge sulle cellule staminali ottiene il 66,4% di sì. Tutti i cantoni l’hanno accettata.
La nuova perequazione finanziaria ha raccolto il 64,4% di consensi. Bocciata solo nei tre cantoni “ricchi” di Zugo, Nidwaldo e Svitto.
Il nuovo regime finanziario è stato accettato dal 73,8%. Solo in cantone di Zugo l’ha bocciato.
La percentuale di votanti è stata del 35,7%. Si tratta del tasso più debole dal febbraio 2003, quando il minimo storico del 26,7% toccato nel 1972 era stato quasi uguagliato.
I temi complessi in votazione hanno tenuto lontani molti cittadini, ma chi si è recato alle urne si è fidato delle indicazioni di governo e parlamento.
Questa volta non c’è stato alcun fossato tra le varie parti della Svizzera.

In conformità con gli standard di JTI
Altri sviluppi: SWI swissinfo.ch certificato dalla Journalism Trust Initiative









Potete trovare una panoramica delle discussioni in corso con i nostri giornalisti qui.
Se volete iniziare una discussione su un argomento sollevato in questo articolo o volete segnalare errori fattuali, inviateci un'e-mail all'indirizzo italian@swissinfo.ch.